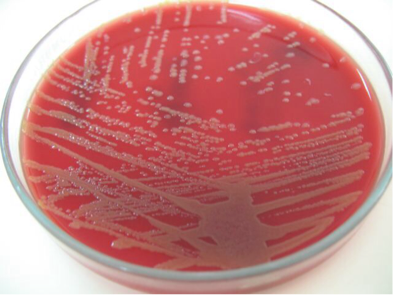

Sign up for FlowVella
Sign up with FacebookAlready have an account? Sign in now
By registering you are agreeing to our
Terms of Service
Loading Flow
Eubacteria=pantoea agglomerans
~Pantoea agglomerans
~Multicellular
~Nucleus
~Eukaryotic